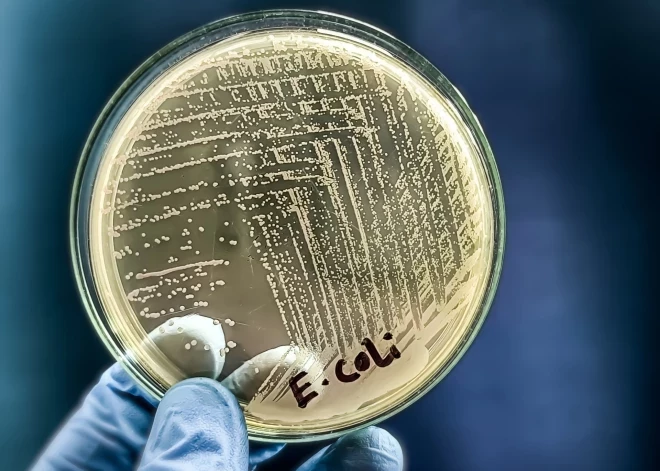

Обнаружено по крайней мере два возможных источника заражения кишечной палочкой

Текущие данные по исследованию заражения кишечной палочкой указывают как минимум на два источника заражения, сообщили сегодня специалисты Центра профилактики и контроля заболеваний (ЦПКЗ).
В ЦПКЗ сообщили, что находятся в контакте с экспертами Европейского центра профилактики и контролю заболеваний (ECDC) по поводу проводимых эпидемиологических мероприятий.
Сегодня вечером в Латвию прибудут два эксперта ECDC - эпидемиолог и бактериолог, которые имеют большой опыт в расследовании вспышек кишечной палочки, чтобы поддержать латвийских специалистов.
По мнению экспертов, в настоящее время маловероятно, что заражение кишечной палочкой произошло вне учебных заведений, так как случаев заболевания у тех, кто не посещал учебные заведения, не наблюдается.
Анализ заболеваемости в настоящее время не указывает на дальнейшее распространение инфекции среди контактных лиц. Вместе с тем образовательным учреждениям и родителям рекомендуется внимательно следовать рекомендациям специалистов: образовательным учреждениям необходимо установить причины отсутствия детей в группе, где был зарегистрирован случай заболевания, а также причины отсутствия персонала, контактировавшего с заболевшим ребенком. Также нельзя допускать в образовательное учреждение детей с болями в животе, диареей, тошнотой, рвотой или повышенной температурой тела. Заболевшего ребенка следует немедленно изолировать от окружающих и сообщить об этом родителям по телефону.
Уже сообщалось, что в ходе текущей вспышки на данный момент подтверждено 57 случаев заболевания, из них 50 детей и семь взрослых. Всего на данный момент госпитализирован 31 пациент - 30 детей и один взрослый.



